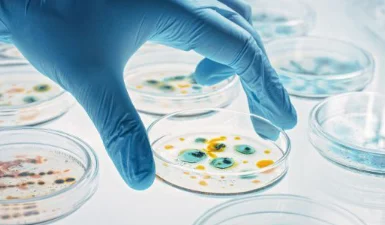

En Wanway Lab realizamos análisis fisicoquímicos, microbiológicos y oncológicos para medicamentos, materias primas y productos cosméticos, asegurando cumplimiento normativo y resultados confiables.
Brindamos servicios de alta calidad en todas las etapas del proceso analítico, ofreciendo soluciones integrales para productos registrados en Chile. Nuestra operación cuenta con resolución de autorización de funcionamiento del ISP, lo que garantiza precisión, seguridad y trazabilidad en cada informe emitido.
Wanway Lab: resultados que entregan confianza y respaldo regulatorio.

En Wanway Lab somos un equipo con más de 30 años de experiencia dedicado a fortalecer la calidad de los medicamentos en Chile. Entregamos análisis confiables y un servicio de excelencia que aporta seguridad, trazabilidad y respaldo técnico.
Trabajamos como socios estratégicos de nuestros clientes, ofreciendo soluciones integrales y oportunas.
Entregar un servicio de excelencia, aprovechando plenamente nuestros recursos y la experiencia de nuestro equipo, para ser una contribución real al éxito de nuestros clientes, agregando valor y fortaleciendo sus procesos.
Ser un laboratorio líder, reconocido por ofrecer servicios de la más alta calidad y confiabilidad, mejorando continuamente nuestros procesos y relaciones con los clientes, y desarrollando a nuestro equipo como pilar fundamental de nuestro éxito.